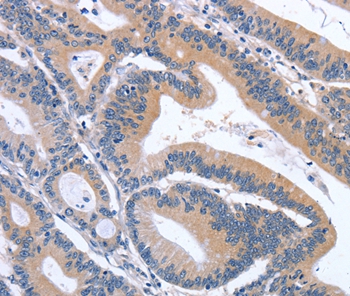

Immunofluorescent staining of human cell line U-2 OS shows localization to vesicles.
Anti-GDF11 Antibody
HPA060985
ApplicationsImmunoCytoChemistry
Product group Antibodies
ReactivityHuman
TargetGDF11
Overview
- SupplierAtlas Antibodies
- Product NameAnti-GDF11
- Delivery Days Customer4
- ApplicationsImmunoCytoChemistry
- CertificationResearch Use Only
- ClonalityPolyclonal
- ConjugateUnconjugated
- Gene ID10220
- Target nameGDF11
- Target descriptiongrowth differentiation factor 11
- Target synonymsBMP-11, BMP11, VHO, growth/differentiation factor 11, GDF-11, bone morphogenetic protein 11
- HostRabbit
- IsotypeIgG
- Protein IDO95390
- Protein NameGrowth/differentiation factor 11
- Scientific DescriptionRecombinant Protein Epitope Signature Tag (PrEST) antigen sequence
- ReactivityHuman
- Storage Instruction-20°C,2°C to 8°C
- UNSPSC41116161